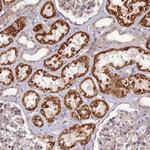
PAGR1 Antibody in Immunohistochemistry (Paraffin) (IHC (P))

Search
Invitrogen
PAGR1 Polyclonal Antibody
{{$productOrderCtrl.translations['antibody.pdp.commerceCard.promotion.promotions']}}
{{$productOrderCtrl.translations['antibody.pdp.commerceCard.promotion.viewpromo']}}
{{$productOrderCtrl.translations['antibody.pdp.commerceCard.promotion.promocode']}}: {{promo.promoCode}} {{promo.promoTitle}} {{promo.promoDescription}}. {{$productOrderCtrl.translations['antibody.pdp.commerceCard.promotion.learnmore']}}
产品信息
PA5-59574
种属反应
宿主/亚型
分类
类型
抗原
偶联物
形式
浓度
规格
纯化类型
保存液
内含物
保存条件
运输条件
RRID
产品详细信息
Immunogen sequence: PAEEDSEDWC VPCSDEEVEL PADGQPWMPP PSEIQRLYEL LAAHGTLELQ AEILPRRPPT PEAQSEEERS DEEPEA
Highest antigen sequence identity to the following orthologs: Mouse - 89%, Rat - 91%.
靶标信息
Steroid receptor co-activators (SRCs) were initially described as nuclear receptor transcription co-activators, but they have recently been determined to co-regulate transcription initiated by other transcription factors. GAS is a recently identified glutamate-rich protein that interacts with SRC1, but not GRIP1 or AIB1, the other two members of the SRC family. GAS can also interact with the alpha subunit of the estrogen receptor (ERalpha), but not other receptors such as the retinoic acid receptor a, suggesting the interaction between GAS and ERalpha is relatively specific. Depletion of GAS by RNA interference in MCF7 cells led to a decrease in the mRNA and protein levels of ER target genes such as pS2, c-Myc and cyclin D1, indicating the role of GAS in the regulation of ER target genes. GAS has also been found to associate with an SET1-like methyltransferase complex specific for H3K4 methylation, suggesting that GAS has multiple roles in transcriptional regulation.
仅用于科研。不用于诊断过程。未经明确授权不得转售。
篇参考文献 (0)
生物信息学
蛋白别名: GAS; glutamate-rich coactivator associated with SRC1; Glutamate-rich coactivator interacting with SRC1; glutamate-rich coactivator interacting with SRC1/NCOA1; PA1; PAXIP1-associated glutamate-rich protein 1; PAXIP1-associated protein 1; PTIP-associated 1 protein; PTIP-associated protein 1
基因别名: C16orf53; GAS; PA1; PAGR1
UniProt ID: (Human) Q9BTK6
Entrez Gene ID: (Human) 79447